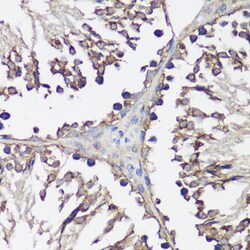
Invitrogen VAMP2 Polyclonal Antibody 100 &mu;L; Unconjugated:Antibodies,

Learn More
Invitrogen™ VAMP2 Polyclonal Antibody
Rabbit Polyclonal Antibody
Brand: Invitrogen™ PA588582
Description
Immunogen sequence: MSATAATAPP AAPAGEGGPP APPPNLTSNR RLQQTQAQVD EVVDIMRVNV DKVLERDQKL SELDDRADAL QAGASQFETS AAKLKRKYWW KNLKMMIILG; Positive Samples: 22Rv1, Mouse brain, Mouse lung, Rat brain; Cellular Location: Cell junction, Cell membrane, Cytoplasmic vesicle, Single-pass type IV membrane protein, secretory vesicle, synapse, synaptic vesicle membrane, synaptosome.
The vesicle associated membrane proteins (VAMP) or synaptobrevins are calcium binding proteins specific to eukaryotes. VAMPs, along with synaptosomal associated protein of 25 kDa (SNAP-25) and syntaxin, form the core complex of soluble NSF attachment protein receptor (SNARE) proteins that interact with the soluble proteins N-ethylmaleimide-sensitive factor (NSF) and alpha-SNAP. These membrane associated proteins play a key role in the regulation of vesicle membrane fusion with the plasma membrane. The Clostridium tetani neurotoxin is a metalloprotease with specificity for VAMP. In Alzheimer's disease, VAMP levels of all isoforms appear to be significantly lowered. It is suggested that VAMP-2 is a resident protein of the insulin-sensitive glucose transporter type 4 (GLUT4) compartment and that it is required for GLUT4 vesicle incorporation into the cell surface in response to insulin.
Specifications
| VAMP2 | |
| Polyclonal | |
| Unconjugated | |
| VAMP2 | |
| RATVAMPB; RATVAMPIR; SYB; SYB2; Syb-2; sybII; Synaptobrevin; synaptobrevin 2; Synaptobrevin 2 (vesicle-associated membrane protein VAMP-2); synaptobrevin II; synaptobrevin-2; vamp; Vamp2; VAMP-2; vesicle associated membrane protein 2; vesicle-associated membrane 2; Vesicle-associated membrane protein (synaptobrevin 2); vesicle-associated membrane protein 2; vesicle-associated membrane protein 2 (synaptobrevin 2) | |
| Rabbit | |
| Affinity chromatography | |
| RUO | |
| 22318, 24803, 6844 | |
| -20°C, Avoid Freeze/Thaw Cycles | |
| Liquid |
| ELISA, Immunohistochemistry (Paraffin), Western Blot | |
| 0.42 mg/mL | |
| PBS with 50% glycerol and 0.09% sodium azide; pH 7.3 | |
| P63027, P63044, P63045 | |
| VAMP2 | |
| A synthetic peptide corresponding to a sequence within amino acids 1-100 of human VAMP2 (NP_0550472). | |
| 100 μL | |
| Primary | |
| Human, Mouse, Rat | |
| Antibody | |
| IgG |
Your input is important to us. Please complete this form to provide feedback related to the content on this product.